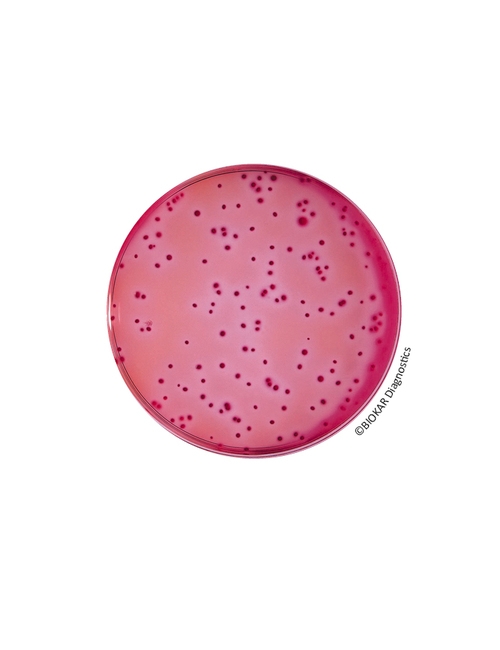
img

VRBL Agar
VRBL Agar
Violet Red Bile Agar (VRBL) gıda ürünlerinde koliform ve termotolerans koliformları tespiti ve sayımı için kullanılan seçici bir besiyeridir.

Ürün Adı: VRBL Agar
Ürün Kodu: BK152GC
Miktar: 5 kg

Ürün Adı: VRBL Agar
Ürün Kodu: BK152HA
Miktar: 500 g
Ürün Adı: VRBL Agar
Ürün Kodu: BM03508
Miktar: 10 şişe x 200 mL

Ürün Adı: VRBL Agar
Ürün Kodu: BM03408
Miktar: 10 şişe x 100 mL
TECHNICAL DATA SHEET
TDS_VRBL AGAR_BK152_BM034_BM035_ENv7
